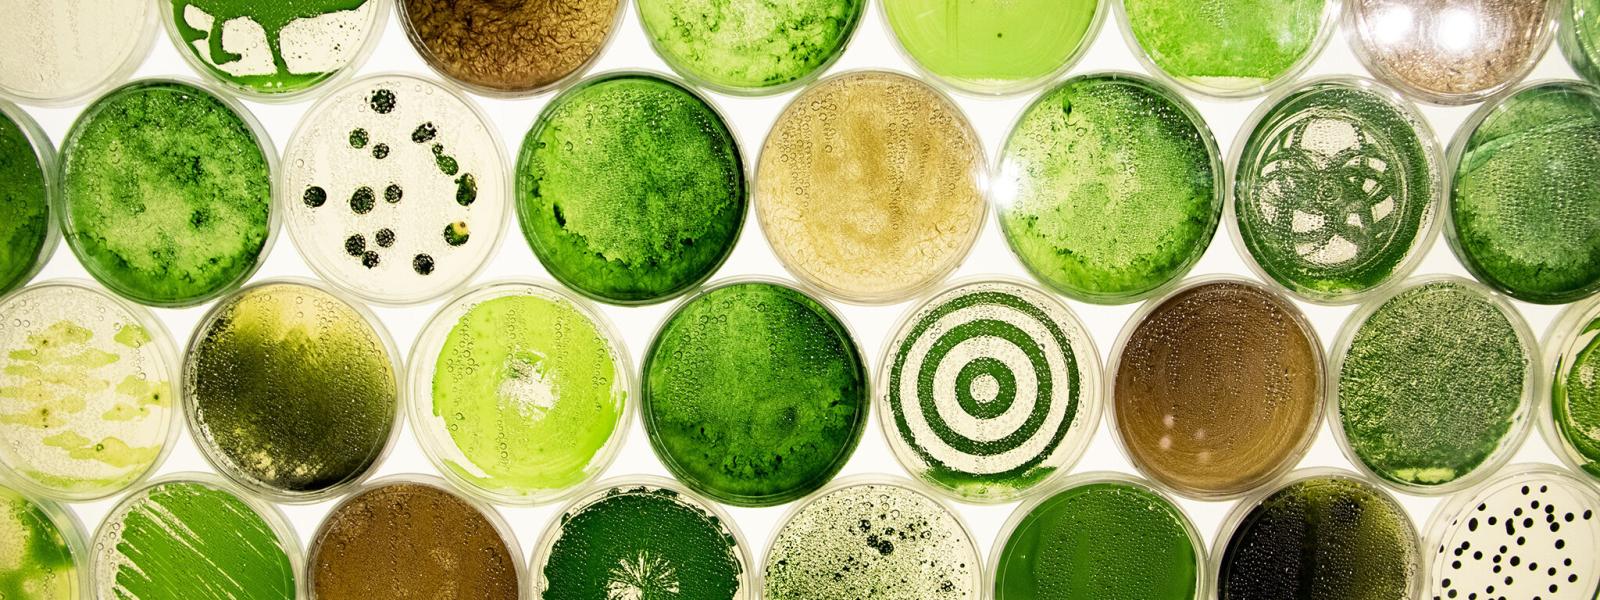
Cyanobacteria

Home
Our Mission
Nature, Environment, Science & Technology (NEST) Studio for the Arts is a network of faculty, students, centers and campus units that combine artistic practice and scientific research to explore our common and disparate ways of observing, recording, experimenting and knowing. A series of cross-campus initiatives allow students to directly engage with faculty mentors and inspire alternate modes of communicating with the public.

About Us
Since its inception at CU Boulder in 2017, NEST (Nature, Environment, Science & Technology) Studio for the Arts has facilitated art-science exhibitions across the state, featuring new research that has manifested in film, sculpture, music, painting, video, virtual reality, and all manner of live performance, including poetry, theater, and dance. Work resulting from NEST support has been presented at scientific conferences, in science journals, and yielded quantitative data in multiple dissertations.
Partnerships with several dozen intuitions, ranging from galleries to public libraries to museums, in Boulder, Denver, Longmont, Broomfield, Arvada, Carbondale, Steamboat, and beyond, have garnered media attention in the New York Times, Colorado Public Radio, Leonardo, the Denverite, the Denver Post, and more. Pre-COVID, NEST’s work compromised more than half of the public-facing press about the arts on campus, more than any art-related department and the School of Music combined and stands as a clear metric of the campus’s outward-facing mission.
NEST has supported more than 80 graduate students’ original research projects with students in: Aerospace Engineering, Art & Art History, Cinema Studies & Moving Image Arts, Critical Media Practices, English, Evolutionary Biology, Geological Sciences, History, Mathematics, Mechanical Engineering, Music, Philosophy, Psychology and Neuroscience, Theatre and Dance, and beyond.
If you’d like to stay in touch and know more about NEST’s events and news, please look for updates here and follow us on Facebook and Instagram.